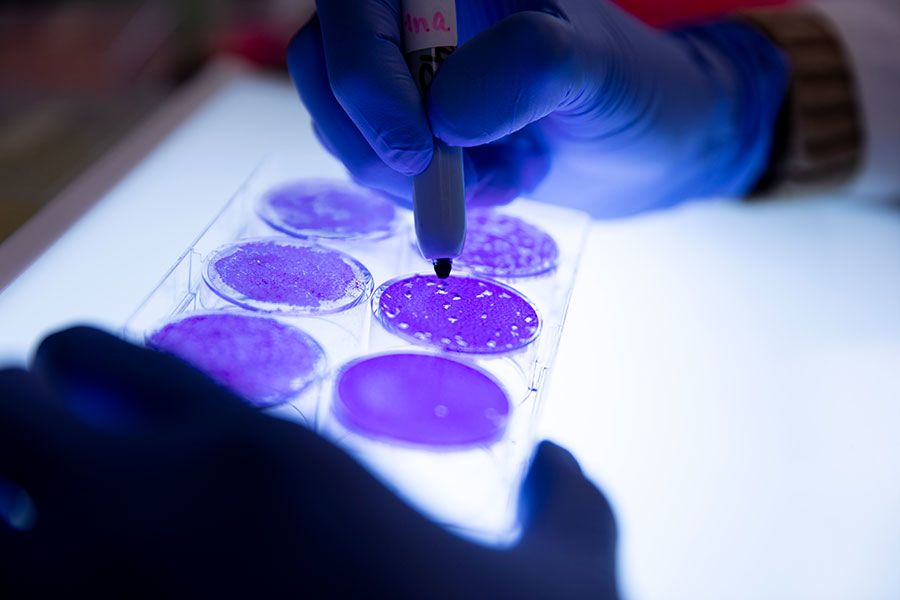

University of Georgia startups changing lives through discovery and innovation
Research-driven enterprises make UGA a national leader
in products to market for nearly a decade.

For the eighth straight year, the University of Georgia has placed among the top five U.S. universities for the number of commercial products created from its research, a distinction that demonstrates the institution’s commitment to tackling more of the world’s greatest challenges in pursuit of a better tomorrow.
The development of new products at UGA has sparked the launch of hundreds of successful companies, which have moved closer to their full market potential through support from the university’s robust startup incubator.
From researching a new treatment for stroke to developing treatments for COVID-19, UGA faculty and researchers work tirelessly to ensure their research discoveries benefit society.
New treatment for stroke

Based on the research of UGA professor Steven Stice, Aruna Bio is the first company to commercialize a product derived from human pluripotent stem cells, and it is now using this original stem cell technology as a basis for preclinical human therapeutics and drug delivery, with a special focus on stroke.
Researchers at Aruna Bio have designed a stroke treatment in the form of an injection that contains proteins and other biological material captured from neural stem cells. And the results speak for themselves.
Using their model, the team has shown that induced neural stem cells, or iNSCs, can replace stroke-damaged brain tissue and stimulate neuroplasticity — the brain’s ability to naturally repair itself.
Every year, nearly 800,000 people in the U.S. have a stroke, and one in every six deaths from cardiovascular disease is due to stroke, according to the Centers for Disease Control and Prevention.
It’s been almost a quarter century since the first drug was approved for stroke. But what’s even more striking is that only a single drug remains approved today.
“We could touch a lot of people if this research is successful,” said Tracey Worthington Stice, Aruna Bio’s executive vice president. “The impact of these results affects not only patients, but their families and communities as well.”

Tracey Worthington Stice and Steven Stice are the co-founders of research startup ArunA Bio.
Tracey Worthington Stice and Steven Stice are the co-founders of research startup ArunA Bio.
Fighting COVID
Founded by UGA researcher Biao He, CyanVac is developing vaccines and treatments for deadly infections such as rabies, tuberculosis, HIV and COVID-19 based on a viral delivery platform containing modified strains of a virus called parainfluenza virus 5, or PIV5.
He’s lab used this technology to develop an intranasal COVID-19 vaccine candidate that is currently under evaluation in Phase 1 human clinical trials.
He and his collaborators developed the vaccine by inserting a portion of the SARS-CoV-2 spike protein into PIV5, which is thought to contribute to upper respiratory infections in dogs but is completely harmless to humans.
The modified PIV5 virus acts as a delivery vehicle that produces proteins found in the coronavirus and prompts the immune system to mount a defense — ultimately promoting an immunity to infection.
The research team has shown in other studies that this vaccine platform can completely protect experimental animals from another dangerous coronavirus disease called Middle Eastern Respiratory Syndrome, or MERS, which was first reported in Saudi Arabia in 2012.
“We have been developing this vaccine platform for more than 20 years, and we began working on new vaccine formulations to combat COVID-19 during the early days of the pandemic,” He said. “Our preclinical data show that this vaccine not only protects against infection, but also significantly reduces the chances of transmission.”

UGA researcher Biao He founded the startup company CyanVan in 2015.
UGA researcher Biao He founded the startup company CyanVan in 2015.

Professor Biao He works with Ph.D. student Maria Huertas-Diaz in his lab in February 2020. He developed a COVID-19 vaccine candidate that has proven successful in early test models.
Professor Biao He works with Ph.D. student Maria Huertas-Diaz in his lab in February 2020. He developed a COVID-19 vaccine candidate that has proven successful in early test models.
Making the world a safer place

MuniRem founder and UGA professor of environmental geochemistry Valentine Nzengung developed a product to safely neutralize explosives and chemical warfare agents with no hazardous byproducts.
Short for “munitions remediation,” MuniRem is a white chemical mixture that, in its bulk form, looks a bit like flour. To use it, all technicians have to do is combine MuniRem with water and introduce it directly to explosive materials. This begins a very fast chemical reaction that neutralizes the explosives in minutes.
More importantly to Nzengung, the byproducts of the complete chemical reaction are all nonhazardous. So not only are the explosives easy to dispose of, but MuniRem can also be used to decontaminate soil and water in places like bomb ranges, mines or munitions factories where dangerous residues have accumulated over many years.
“When I talk with people about explosives, most of them immediately think of military ordnance like bombs or missiles, but explosives are far more common than you might think,” Nzengung said. “Mining and construction companies, for example, use explosives to move earth. There are large numbers of confiscated fireworks in warehouses that could be dangerous. Even the airbag in your car relies on a small explosive charge to inflate the bags quickly. So, there are a tremendous number of applications for this technology.”

A project engineer flushes the interior of Civil War artillery shells with a mixture of water and MuniRem. Valentine Nzengung and MuniRem personnel worked with the U.S. Army Corps of Engineers to neutralize Civil War-era artillery rounds recovered from the bottom of Georgia’s Savannah River.
A project engineer flushes the interior of Civil War artillery shells with a mixture of water and MuniRem. Valentine Nzengung and MuniRem personnel worked with the U.S. Army Corps of Engineers to neutralize Civil War-era artillery rounds recovered from the bottom of Georgia’s Savannah River.

Valentine Nzengung and MuniRem personnel worked with the U.S. Army Corps of Engineers to neutralize Civil War-era artillery rounds recovered from the bottom of Georgia’s Savannah River.
Valentine Nzengung and MuniRem personnel worked with the U.S. Army Corps of Engineers to neutralize Civil War-era artillery rounds recovered from the bottom of Georgia’s Savannah River.
Continued growth

These and many other successes are driven by strategic investments in the university’s Innovation District initiative, a coordinated effort to expand UGA’s economic impact through entrepreneurship, research commercialization and partnerships with the community and industries.
Many of the products that reach the market are developed or perfected in UGA startup companies, and funding during the 2020 fiscal year for UGA startups increased more than 60% from the previous year and more than twice the amount received in fiscal year 2018.
The university recently renovated and opened the Delta Innovation Hub with support of a $5 million commitment from the Delta Air Lines Foundation. Located in the heart of UGA’s North Campus, the Delta Innovation Hub provides a creative space where faculty, students, community members, and industry partners can collaborate and innovate on commercial products.
The university has also enhanced support of entrepreneurial efforts with a multiyear capital plan to build, renovate and modernize hundreds of thousands of square feet devoted to research and innovation.
In December, the university celebrated the completion of the first phase of its Interdisciplinary Science, Technology, Engineering and Math Research Complex. The 100,000-square-foot I-STEM building features flexible, open lab spaces designed to promote collaboration and elevate UGA’s expanding lab-intensive research activities, particularly within the disciplines of chemistry, engineering and material sciences. It will soon be united with a Phase 2 building currently under construction.
UGA’s investments in interdisciplinary research will ultimately fuel its next generation of products and services designed to improve the quality of life for people around the world.

Other Research at UGA

This content was paid for and created by The University of Georgia. The editorial staff of The Chronicle had no role in its preparation. Find out more about paid content.


